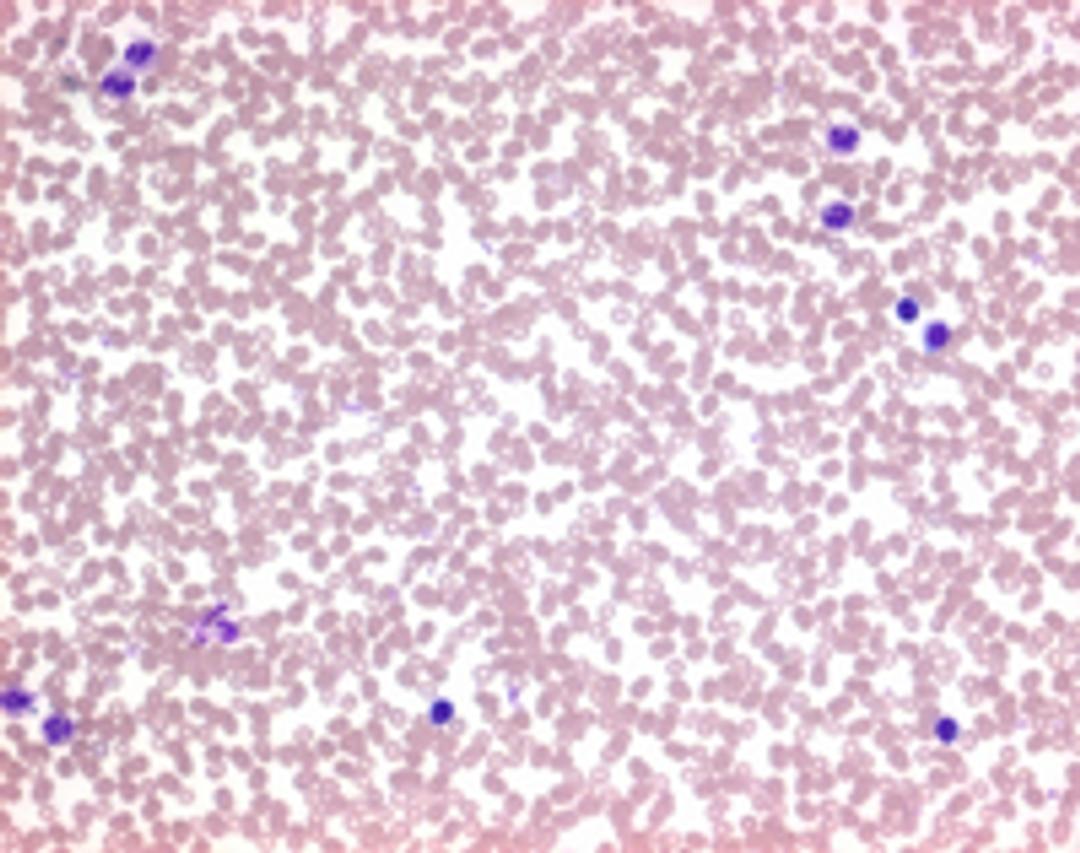
Auto-Hemacolor® - Merck KGaA, Darmstadt, Germany - Clinical Diagnostics

Auto-Hemacolor®
Cytological Staining Reagents

The supplier does not provide quotations for this product through SelectScience. You can search for similar products in our Product Directory.
The Auto-Hemacolor®system was developed for the automatic staining of blood and bone marrow smears in conjunction with the HEMA-TEK (Siemens Healthcare Diagnostics) slider stainer. The kit contains a staining solution, a buffer and a washing solution. Staining is achieved by the alkaline dye (azure) binding to the acidic builders of the cells, e.g. chromatin, spongioplasm, and the acidic dye (eosin) binding to the alkaline constituents, e.g. cytoplasm. It is developed and registered as CE / IVD product for applications in diagnostics and can be applied for up to 1000 stains.